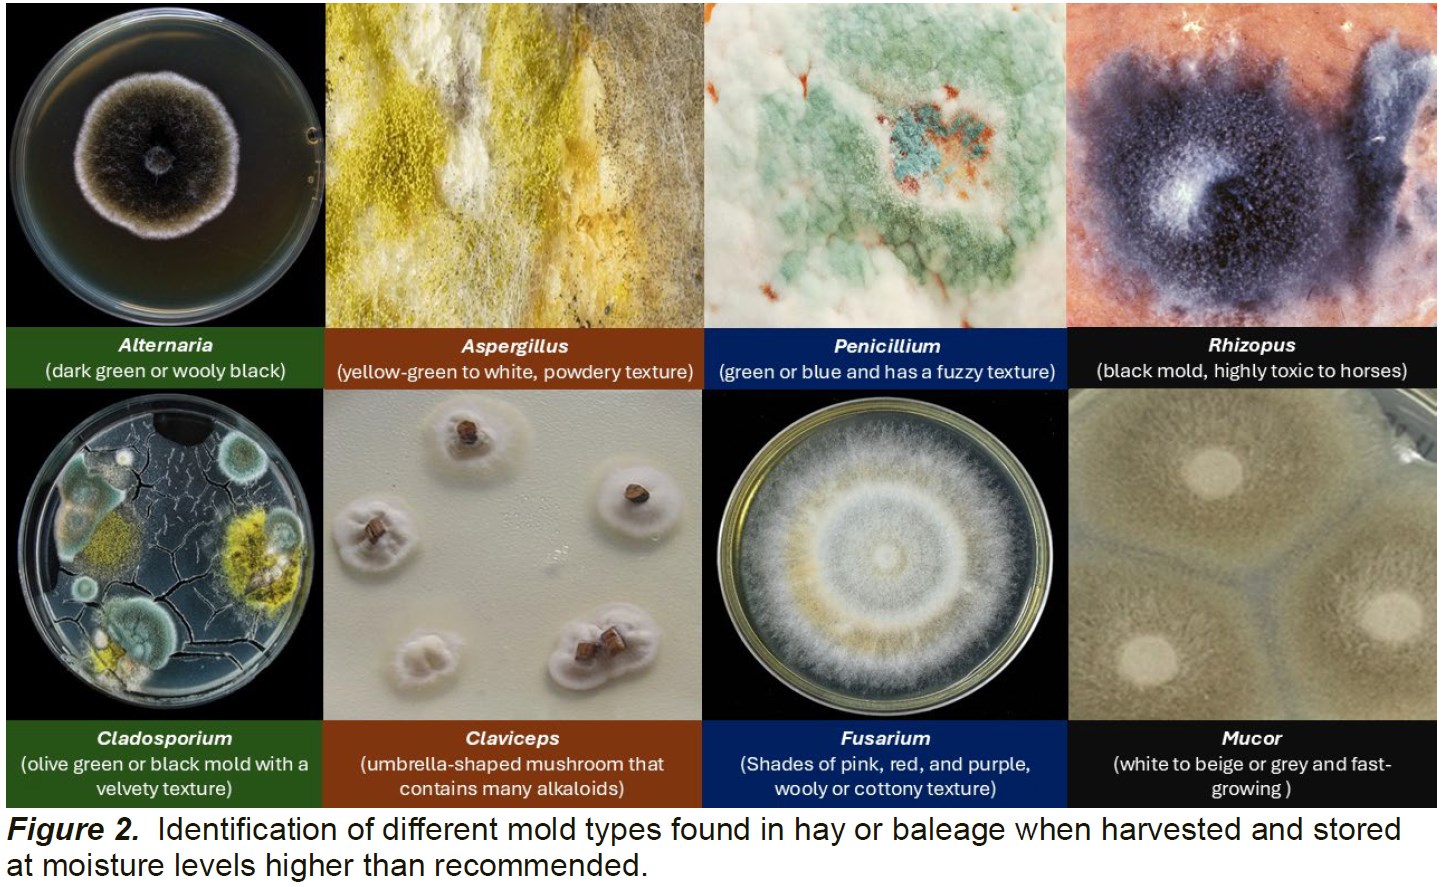
2024_December_.jpg

Posted on December 29, 2024 by Mississippi State University Extension
Source: Farm Progress. The original article is posted here.

Depending on fungal species, moldy hay can be dangerous to different livestock species and should not be fed, but the direct negative effects of moldy hay are difficult to document. Some types of molds produce mycotoxins, which are toxic compounds that can cause health problems in livestock. Some of the issues caused by moldy hay include feed refusal, low fertility, increased water consumption, poor hair coats, estrogenic effects, lameness, poor kidney or liver function, respiratory problems (pneumonia-like respiratory issues such as hacking or coughing), diarrhea, and colic (horses). Cattle and small ruminants (sheep and goats) are less affected (except during pregnancy) by moldy hay since many mycotoxins are broken down in the rumen, but it can cause mycotic abortions or aspergillosis. Horses, which are cecal digesters, are at the highest risk of mold susceptibility among common livestock. They can develop a respiratory disease called Recurrent Airway Obstruction (RAO), also known as heaves. Symptoms include coughing, nasal discharge, and labored breathing. Lactating dairy cows should never be fed moldy feeds to avoid any trace of mycotoxins in milk. Across all species, pregnant animals and young animals are at higher risk along animals in poor condition are more likely to be affected by moldy hay. In livestock producers, spores in moldy hay can cause a condition called “farmer’s lung,” where the fungus can grow in lung tissue after breeding too many spores.
Related: The Sacco Brothers: A legacy of sustainable ranching in Utah
Feeding moldy hay to livestock is a tough decision and testing for molds in forages is quite difficult. The only way to determine the type and amount of spores and the presence of mycotoxins in hay is by taking a sample and sending it to a diagnostic laboratory for analysis. Visual appraisal (smell and color) might provide visual cues to determine mold severity but might not provide a complete picture and the use of a black light is not the best method of detection and assessment. If the presence of mycotoxins is unable to be verified, it is important to carefully monitor herd health regarding reproductive efficiency, feed utilization and gain, and overall health status. Even if mycotoxins are not present in the hay, mold can lower the nutritional value such as lower digestibility of feeds, and result in nutrient loss such as total digestible nutrients (TDN) and lower vitamin levels (A, D3, E, K, and thiamine). Mold can typically appear as a white, gray, or black powdery substance on the surface of the hay. Large mold problems that have unusual mold colors are more cause for concern as they may potentially produce mycotoxins. The most common types include Alternaria (dark green or wooly black), Aspergillus (yellow-green to white, powdery texture), Pen-icillium (green or blue and has a fuzzy texture), Cladosporium (olive green or black mold with a velvety texture), Clavi-ceps (umbrella-shaped mushroom that contains a large number of alkaloids), Fusarium (Shades of pink, red, and purple, wooly or cottony texture), Mucor (white to beige or grey and fast-growing while older colonies become grey to brown due to the development of spores), and Rhizopus (black, highly toxic to horses) (Fig. 2). These molds can produce mycotoxins which can be harmful to animals if ingested in large quantities. Members of the genera Alternaria, Aspergillus, Fusarium, and Penicillium produce mycotoxins that can cause direct toxicity or suppress the immune sys-tem. The Mucor species do not pro-duce mycotoxins, but along with some species of Aspergillus, can cause mycotic abortion in cattle.
Related: Gudmundsen Sandhills Laboratory recognized by IACUC with Outstanding Animal Care Award
Related: Gudmundsen Sandhills Laboratory recognized by IACUC with Outstanding Animal Care Award
Although some producers might consider mixing moldy hay with other types of supplemental feed to dilute the problem, it could increase the risk of eating hay that would normally be refused. There are about 400 different known mycotoxins and unfortunately, they are not easily verified, as their distribution in hay may be highly variable. The mycotoxins of greatest concern are those produced by Aspergillus (aflatoxin, gliotoxin, fumitremorgens, fumigaclavines, ochratoxin A), Fusarium (fumonisins, deoxynivalenol “vomitoxin’, zearalenone, T-2 toxin), and Penicillium (PR toxin, mycophenolic acid, roque-fortine C, patulin). Ochratoxin is typically associated with only death in young calves. In mature animals, this toxin is rapidly degraded in the rumen. Fumigatus is a mycotoxin that is frequently detected in hay. When consumed by livestock, it can exhibit symptoms of protein deficiency or malnutrition (poor hair coat, immunodeficiency, and poor performance).
No hay sample will be exempt from mold. Most forage testing laboratories can test hay (and other feedstuffs) for different types and amounts of spores and specific mycotoxins. The sample is collected and submitted like a hay analysis for nutrient value. The cost ranges from $60 to $90 per sample and it might take about 5 to 10 days to complete. The results of the mold spore counts are provided as “colony forming units per gram (cfu/g).” The hay feeding risks are classified based on the amount of cfu/g: (1) low risk (under 500,000), (2) relatively safe (500,000 to 1 million), (3) feed with caution (1 to 2 million), (4) closely observe animals and performance (2 to 3 million), (5) dilute with other feeds (3 to 4 million), and (6) discontinue feeding (over 5 million). For more informed decisions about risk and cautions, consult with your nutritionist about safe levels depending on the livestock growth stage.
Many of the mold issues and the mycotoxin issues start in the field before or during baling. Although it might be too late in the season, mold can be prevented by baling at the right moisture (12 – 18%), stacking hay in well-ventilated areas, alternating bales so air can circulate, avoiding placing tarps tightly and completely enclosing the hay that prevents air movement, not stacking hay too high, using a hay preservative if hay is baled too wet, and inspecting the hay for mold before feeding it to animals. Moldy hay becomes less palatable, which can result in lower feed intake or higher animal refusal. Reduced feed intake can lead to poor weight gain, decreased milk production, and diminished animal performance (more susceptible to health issues and nutritional deficiencies). Use common sense and good observation as your best decision aids concerning feeding or testing moldy hay.